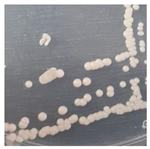
Foods 10 02619 i001

Antifungal and Aflatoxin-Reducing Activity of β-Glucan Isolated from Pichia norvegensis Grown on Tofu Wastewater
Abstract
1. Introduction
2. Materials and Methods
2.1. Native Yeast Isolation and Characterization
2.2. β-Glucan Extraction from Native Yeast Cell Wall
2.3. Antifungal Activity Test towards A. flavus
2.4. Aflatoxin-Reducing Activity Test
3. Results
3.1. Isolation and Identification of Native Yeast from Tofu Wastewater
3.2. Phylogenetic Tree Reconstruction of Native Yeast Isolated from Tofu Wastewater
3.3. Pichia norvegensis NYI Growth
3.4. Production of β-Glucan from Tofu Wastewater by Native Yeast Isolate
3.5. Antifungal Activity of Native Yeast Isolate and β-Glucan
3.6. Aflatoxin-Reducing Activity of Native Yeast and β-Glucan
4. Discussion
4.1. Isolation and Identification Native Yeast from Tofu Wastewater
4.2. Phylogenetic Tree Reconstruction of Native Yeast Isolated from Tofu Wastewater
4.3. Pichia norvegensis NYI Growth
4.4. Production of β-Glucan from Tofu Wastewater by Native Yeast Isolate
4.5. Antifungal Activity of Native Yeast Isolate and β-Glucan
4.6. Aflatoxin-Reducing Activity of Native Yeast and β-Glucan
5. Conclusions
Author Contributions
Funding
Acknowledgments
Conflicts of Interest
References
- Faisal, M.; Gani, A.; Mulana, F.; Daimon, H. Treatment and Utilization of Industrial Tofu Waste in Indonesia. Asian J. Chem. 2016, 28, 501–507. [Google Scholar] [CrossRef]
- Widayat, W.; Plilia, J.; Wibisono, J. Liquid Waste Processing of Tofu Industry for Biomass Production as Raw Material Biodiesel Production. IOP Conf. Ser. Earth Environ. Sci. 2019, 248, 012064. [Google Scholar] [CrossRef]
- Persulessy, A.E.; Rosmalina, R.T.; Hartati, E.; Putra, R.D. Tofu’s Liquid waste treatment by continuous vermibiofilter column-type reactor. IOP Conf. Ser. Earth Environ. Sci. 2020, 483, 012014. [Google Scholar] [CrossRef]
- Singh, A.; Banerjee, R. Value addition to soybean whey through microbial and enzymatic intervention. IJBT 2018, 173, 397–401. [Google Scholar]
- Maryana, L.; Anam, S.; Nugrahani, A.W. Single cell protein production from Rhizopus oryzae culture using tofu liquid waste medium [Produksi protein sel tunggal dari kultur Rhizopus oryzae dengan medium limbah cair tahu]. J. Farm. Galen. Galen. J. Pharm. E-J. 2016, 2, 132–137. [Google Scholar] [CrossRef]
- Utami, L.A.; Suprihadi, A. Utilization of Tofu Waste as a Growth Media for Aspergillus flavus DUCC-K225 for Protease Enzyme Production [Pemanfaatan Limbah Tahu sebagai Media Pertumbuhan Aspergillus flavus DUCC-K225 untuk Produksi Enzim Protease]. Berk. Bioteknol. 2018, 1, 1–6. [Google Scholar]
- Febriyanti, A.E.; Sari, C.N.; Adisyahputra, A. Effectiveness of Growth Media Commercial Yeast (Saccharomyces cerevisir Bioethanol Fermentati Water Hyacinth (Eicchornia crassipes) [Efektivitas Media Pertumbuhan Khamir Komersial (Saccharomyces cerevisiae) untuk Fermentasi Bioetanol dari Eceng Gondok (Eichhornia crassipes)]. BIOMA 2017, 12, 112. [Google Scholar] [CrossRef]
- Xu, Y.; Ye, Q.; Zhang, H.; Yu, Y.; Li, X.; Zhang, Z.; Zhang, L. Naturally Fermented Acid Slurry of Soy Whey: High-Throughput Sequencing-Based Characterization of Microbial Flora and Mechanism of Tofu Coagulation. Front. Microbiol. 2019, 10, 1088. [Google Scholar] [CrossRef] [PubMed]
- Li, L.; Feng, J.; Liu, L.; Fei, Y.; Liu, D. Isolation and Identification of Yeast from Acidic Tofu Whey and Its Application to Soy Yogurt. Mod. Food Sci. Technol. 2016, 32, 173–179. [Google Scholar] [CrossRef]
- Kim, W.-C.; So, J.-H.; Kim, S.-I.; Shin, J.-H.; Song, K.-S.; Yu, C.-B.; Kho, Y.-H.; Rhee, I.-K. Isolation, Identification, and Characterization of Pichia guilliermondii K123-1 and Candida fermentati SI, Producing Isoflavone β-Glycosidase to Hydrolyze Isoflavone Glycoside Efficiently, from the Korean Traditional Soybean Paste. J. Appl. Biol. Chem. 2009, 52, 163–169. [Google Scholar] [CrossRef][Green Version]
- Suliantari; Suryaatmadja, S.L.; Kusumaningrum, H. Microbial Content and Diversity in Several Tempe from Bogor Areas [Kandungan dan Keragaman Mikroba Beberapa Tempe dari Daerah Bogor]. In Proceedings of the Prosiding Seminar Hasil-Hasil PPM IPB 2015, Bogor, Indonesia, 1–2 December 2015; Institut Pertanian Bogor: Bogor, Indonesia, 2015; Volume 1, pp. 229–237. [Google Scholar]
- Narusaka, M.; Minami, T.; Iwabuchi, C.; Hamasaki, T.; Takasaki, S.; Kawamura, K.; Narusaka, Y. Yeast Cell Wall Extract Induces Disease Resistance against Bacterial and Fungal Pathogens in Arabidopsis thaliana and Brassica Crop. PLoS ONE 2015, 10, e0115864. [Google Scholar] [CrossRef] [PubMed]
- Lipke, P.N.; Ovalle, R. Cell Wall Architecture in Yeast: New Structure and New Challenges. J. Bacteriol. 1998, 180, 3735–3740. [Google Scholar] [CrossRef] [PubMed]
- Kapteyn, J.C.; Montijin, R.C.; Vink, E.; de la Cruz, J.; Llobell, A.; Douwes, J.E.; Shimoi, H.; Lipke, P.N.; Klis, F.M. Retention of Saccharomyces cerevisiae cell wall proteins through a phosphodiester-linked β -1,3-/ β -l,6-glucan heteropolymer. Glycobiology 1996, 6, 337–345. [Google Scholar] [CrossRef]
- Garcia-Rubio, R.; de Oliveira, H.C.; Rivera, J.; Trevijano-Contador, N. The Fungal Cell Wall: Candida, Cryptococcus, and Aspergillus Species. Front. Microbiol. 2020, 10, 2993. [Google Scholar] [CrossRef] [PubMed]
- Zhu, F.; Du, B.; Xu, B. A critical review on production and industrial applications of beta-glucans. Food Hydrocoll. 2016, 52, 275–288. [Google Scholar] [CrossRef]
- Wang, Q.; Sheng, X.; Shi, A.; Hu, H.; Yang, Y.; Liu, L.; Fei, L.; Liu, H. β-Glucans: Relationships between Modification, Conformation and Functional Activities. Molecules 2017, 22, 257. [Google Scholar] [CrossRef]
- De Simone, N.; Pace, B.; Grieco, F.; Chimienti, M.; Tyibilika, V.; Santoro, V.; Capozzi, V.; Colelli, G.; Spano, G.; Russo, P. Botrytis cinerea and Table Grapes: A Review of the Main Physical, Chemical, and Bio-Based Control Treatments in Post-Harvest. Foods 2020, 9, 1138. [Google Scholar] [CrossRef]
- Masih, E.I.; Slezack-Deschaumes, S.; Marmaras, I.; Barka, E.A.; Vernet, G.; Charpentier, C.; Adholeya, A.; Paul, B. Characterisation of the yeast Pichia membranifaciens and its possible use in the biological control of Botrytis cinerea, causing the grey mould disease of grapevine. FEMS Microbiol. Lett. 2001, 202, 227–232. [Google Scholar] [CrossRef]
- Landim, P.G.C.; Correia, T.O.; Silva, F.D.A.; Nepomuceno, D.R.; Costa, H.P.S.; Pereira, H.M.; Lobo, M.D.P.; Moreno, F.B.M.B.; Brandão-Neto, J.; Medeiros, S.C.; et al. Production in Pichia pastoris, antifungal activity and crystal structure of a class I chitinase from cowpea (Vigna unguiculata): Insights into sugar binding mode and hydrolytic action. Biochimie 2017, 135, 89–103. [Google Scholar] [CrossRef]
- Vetvicka, V. Effects of β-glucan on some environmental toxins: An overview. Biomed. Pap. Med. Fac. Univ. Palacky Olomouc. Czech. Repub. 2014, 158, 1–4. [Google Scholar] [CrossRef]
- Kaminski, K.; Skora, M.; Krzyściak, P.; Stączek, S.; Zdybicka-Barabas, A.; Cytryńska, M. Synthesis and Study of Antifungal Properties of New Cationic Beta-Glucan Derivatives. Pharmaceuticals 2021, 14, 838. [Google Scholar] [CrossRef] [PubMed]
- Muccilli, S.; Restuccia, C. Bioprotective Role of Yeasts. Microorganisms 2015, 3, 588–611. [Google Scholar] [CrossRef] [PubMed]
- Kusumaningtyas, E. Local isolate of Saccharomyces cerevisiae as biocompetitive agent of Aspergillus flavus [Isolat Lokal Saccharomyces cerevisiae sebagai Biokompetitor Aspergillus flavus]. JITV 2006, 11, 7. [Google Scholar]
- Persons, K.; Raines, J.M.; Rodriguez, J.M. Antagonistic effects of Saccharomyces cerevisiae on the growth of Aspergillus flavus and Aspergillus parasiticus at varying temperatures. Mycology 2013, 4, 38–43. [Google Scholar] [CrossRef]
- Chang, P.-K.; Hua, S.; Sarreal, S.; Li, R. Suppression of Aflatoxin Biosynthesis in Aspergillus flavus by 2-Phenylethanol Is Associated with Stimulated Growth and Decreased Degradation of Branched-Chain Amino Acids. Toxins 2015, 7, 3887–3902. [Google Scholar] [CrossRef]
- Gonçalves, B.L.; Gonçalves, C.; Rosim, R.E.; Oliveira, C.A.F.; Corassin, C.H. Evaluations of Different Sources of Saccharomyces cerevisiae to Binding Capacity of Aflatoxin B1 Utilizing their Adsorption Isotherms. J. Food Chem. Nanotechnol. 2017, 3, 126–132. [Google Scholar] [CrossRef]
- Joannis-Cassan, C.; Tozlovanu, M.; Hadjeba-Medjdoub, K.; Ballet, N.; Pfohl-Leszkowicz, A. Binding of Zearalenone, Aflatoxin B1, and Ochratoxin A by Yeast-Based Products: A Method for Quantification of Adsorption Performance. J. Food Prot. 2011, 74, 1175–1185. [Google Scholar] [CrossRef]
- Grumezescu, A. Nutraceuticals, 1st ed.; Academic Press: Cambridge, MA, USA, 2016; ISBN 978-0-12-804376-9. [Google Scholar]
- Yiannikouris, A.; André, G.; Poughon, L.; François, J.; Dussap, C.-G.; Jeminet, G.; Bertin, G.; Jouany, J.-P. Chemical and Conformational Study of the Interactions Involved in Mycotoxin Complexation with β- d -Glucans. Biomacromolecules 2006, 7, 1147–1155. [Google Scholar] [CrossRef] [PubMed]
- Carvajal-Moreno, M. Metabolic Changes of Aflatoxin B1 to become an Active Carcinogen and the Control of this Toxin. Immunome Res. 2015, 11, 1. [Google Scholar] [CrossRef]
- Lalah, J.O.; Omwoma, S.; Orony, D.A.O. Aflatoxin B1: Chemistry, Environmental and Diet Sources and Potential Exposure in Human in Kenya; IntechOpen: London, UK, 2019; ISBN 978-1-83880-256-1. [Google Scholar]
- Bzducha-Wróbel, A.; Bryła, M.; Gientka, I.; Błażejak, S.; Janowicz, M. Candida utilis ATCC 9950 Cell Walls and β(1,3)/(1,6)-Glucan Preparations Produced Using Agro-Waste as a Mycotoxins Trap. Toxins 2019, 11, 192. [Google Scholar] [CrossRef]
- Roostita, L.B.; Fleet, G.H.; Wendry, S.P.; Apon, Z.M.; Gemilang, L.U. Determination of Yeasts Antimicrobial Activity in Milk and Meat Products. Adv. J. Food Sci. Technol. 2011, 3, 442–445. [Google Scholar]
- Utama, G.L.; Irena, F.; Lembong, E.; Kayaputri, I.L.; Tensiska, T.; Balia, R.L. The Utilization of Vegetable and Fruit Wastes for Saccharomyces cerevisieae Cell Wall Based β-Glucan Production with Antioxidant Activity. Acta Univ. Agric. Silvic. Mendel. Brun. 2020, 68, 119–127. [Google Scholar] [CrossRef]
- Utama, G.L.; Tyagita; Krissanti, I.; Wira, D.W.; Balia, R.L. Stress Tolerance Yeast Strain From Papaya Wastes for Bioethanol Production. Int. J. Geomate. 2019, 17, 97–103. [Google Scholar] [CrossRef]
- Utama, G.L.; Kurniawan, M.O.; Natiqoh, N.; Balia, R.L. Species Identification of Stress Resistance Yeasts Isolated from Banana Waste for Ethanol Production. IOP Conf. Ser. Earth Environ. Sci. 2019, 306, 012021. [Google Scholar] [CrossRef]
- Salari, R.; Salari, R. Investigation of the Best Saccharomyces cerevisiae Growth Condition. Electron. Physician 2017, 9, 3592–3597. [Google Scholar] [CrossRef]
- Pengkumsri, N.; Sivamaruthi, B.S.; Sirilun, S.; Peerajan, S.; Kesika, P.; Chaiyasut, K.; Chaiyasut, C. Extraction of β-glucan from Saccharomyces cerevisiae: Comparison of different extraction methods and in vivo assessment of immunomodulatory effect in mice. Food Sci. Technol. 2016, 37, 124–130. [Google Scholar] [CrossRef]
- Novrianti, V.; Harahap, I.; Elsie, E. Antifungal Activity Test of Cinnamon Extract (Cinnamomun burmani) on Growth of Aspergillus flavus and Fusarium moniliforme. Bioscience 2019, 3, 106–112. [Google Scholar] [CrossRef]
- Ernst, E.J.; Rogers, P.D. Antifungal Agents: Methods and Protocols; Humana Press: Totowa, NJ, USA, 2005; ISBN 1-58829-277-0. [Google Scholar]
- Gajjar, D.U.; Pal, A.K.; Ghodadra, B.K.; Vasavada, A.R. Microscopic Evaluation, Molecular Identification, Antifungal Susceptibility, and Clinical Outcomes in Fusarium, Aspergillus and, Dematiaceous Keratitis. BioMed Res. Int. 2013, 2013, 1–10. [Google Scholar] [CrossRef][Green Version]
- Raharjanti, D.S. Inhibition of Growth of Aspergillus Parasiticus and Reduction of Aflatoxin by Yeast Molds and Yeast Tape [Penghambatan Pertumbuhan Aspergillus Parasiticus dan Reduksi Aflatoksin oleh Kapang dan Khamir Ragi Tape]; Institut Pertanian Bogor: Bogor, Indonesia, 2006. [Google Scholar]
- Zhang, K.; Banerjee, K. A Review: Sample Preparation and Chromatographic Technologies for Detection of Aflatoxins in Foods. Toxins 2020, 12, 539. [Google Scholar] [CrossRef]
- Faucet-Marquis, V.; Joannis-Cassan, C.; Hadjeba-Medjdoub, K.; Ballet, N.; Pfohl-Leszkowicz, A. Development of an in vitro method for the prediction of mycotoxin binding on yeast-based products: Case of aflatoxin B1, zearalenone and ochratoxin A. Appl. Microbiol. Biotechnol. 2014, 98, 7583–7596. [Google Scholar] [CrossRef]
- Chua, J.-Y.; Liu, S.-Q. Soy whey: More than just wastewater from tofu and soy protein isolate industry. Trends Food Sci. Technol. 2019, 91, 24–32. [Google Scholar] [CrossRef]
- Yu, Y.; Zhu, X.; Shen, Y.; Yao, H.; Wang, P.; Ye, K.; Wang, X.; Gu, Q. Enhancing the vitamin B12 production and growth of Propionibacterium freudenreichii in tofu wastewater via a light-induced vitamin B12 riboswitch. Appl. Microbiol. Biotechnol. 2015, 99, 10481–10488. [Google Scholar] [CrossRef] [PubMed]
- Ebabhi, A.M.; Adekunle, A.A.; Okunowo, W.O.; Osuntoki, A.A. Isolation and characterization of yeast strains from local food crops. J. Yeast Fungal Res. 2013, 4, 38–43. [Google Scholar]
- Khattab, S.; Abdel-Hadi, A.; Abo-Dahab, N.; Atta, O. Isolation, Characterization, and Identification of Yeasts Associated with Foods from Assiut City, Egypt. Br. Microbiol. Res. J. 2016, 13, 1–10. [Google Scholar] [CrossRef]
- McGinnis, M.R.; Tyring, S.K. Introduction to Mycology. In Medical Microbiology; Baron, S., Ed.; University of Texas Medical Branch at Galveston: Galveston, TX, USA, 1996; ISBN 978-0-9631172-1-2. [Google Scholar]
- Amatore, Z.; Gunn, S.; Harris, L.K. An Educational Bioinformatics Project to Improve Genome Annotation. Front. Microbiol. 2020, 11, 2919. [Google Scholar] [CrossRef]
- Koonin, E.V.; Galperin, M.Y. Principles and Methods of Sequence Analysis. In Sequence—Evolution—Function; Springer: Boston, MA, USA, 2003; ISBN 978-1-4757-3783-7. [Google Scholar]
- Aponte, M.; Pepe, O.; Blaiotta, G. Short communication: Identification and technological characterization of yeast strains isolated from samples of water buffalo Mozzarella cheese. J. Dairy Sci. 2010, 93, 2358–2361. [Google Scholar] [CrossRef]
- Botes, A.; Todorov, S.D.; von Mollendorff, J.W.; Botha, A.; Dicks, L.M.T. Identification of lactic acid bacteria and yeast from boza. Process Biochem. 2007, 42, 267–270. [Google Scholar] [CrossRef]
- Büchl, N.R.; Seiler, H. Yeasts and Molds | Yeasts in Milk and Dairy Products. In Encyclopedia of Dairy Sciences; Elsevier: Amsterdam, The Netherlands, 2011; pp. 744–753. ISBN 978-0-12-374407-4. [Google Scholar]
- Lim, S.L.; Tay, S.T. Diversity and killer activity of yeasts in Malaysian fermented food samples. Trop. Biomed. 2011, 28, 438–443. [Google Scholar]
- Ribeiro, P.L.; Rapini, A.; e Silva, U.C.S.; van den Berg, C. Using multiple analytical methods to improve phylogenetic hypotheses in Minaria (Apocynaceae). Mol. Phylogenet. Evol. 2012, 65, 915–925. [Google Scholar] [CrossRef]
- Holmes, S. Bootstrapping Phylogenetic Trees: Theory and Methods. Stat. Sci. 2003, 18, 241–255. [Google Scholar] [CrossRef]
- Lemoine, F.; Domelevo Entfellner, J.-B.; Wilkinson, E.; Correia, D.; Dávila Felipe, M.; De Oliveira, T.; Gascuel, O. Renewing Felsenstein’s Phylogenetic Bootstrap in the Era of Big Data. Nature 2018, 556, 452–456. [Google Scholar] [CrossRef]
- Hidayat, T.; Pancoro, A. Molecular Phylogenetic Studies in Providing Basic Knowledge to Improve Quality of Genetic Resources of Orchid [Kajian Filogenetika Molekuler dan Peranannya dalam Menyediakan Informasi Dasar untuk Meningkatkan Kualitas Sumber Genetik Anggrek]. J. AgroBiogen 2008, 4, 35–40. [Google Scholar] [CrossRef]
- Ganter, P.F.; Quarles, B. Analysis of population structure of cactophilic yeast from the genus Pichia: P. cactophila and P. norvegensis. Can. J. Microbiol. 1997, 43, 35–44. [Google Scholar] [CrossRef]
- Sugita, T.; Takeo, K.; Ohkusu, M.; Virtudazo, E.; Takashima, M.; Asako, E.; Ohshima, F.; Harada, S.; Yanaka, C.; Nishikawa, A.; et al. Fluconazole-Resistant Pathogens Candida inconspicua and C. norvegensis: DNA Sequence Diversity of the rRNA Intergenic Spacer Region, Antifungal Drug Susceptibility, and Extracellular Enzyme Production. Microbiol. Immunol. 2004, 48, 761–766. [Google Scholar] [CrossRef]
- Guitard, J.; Atanasova, R.; Brossas, J.Y.; Meyer, I.; Gits, M.; Marinach, C.; Vellaissamy, S.; Angoulvant, A.; Mazier, D.; Hennequin, C. Candida inconspicua and Candida norvegensis: New Insights into Identification in Relation to Sexual Reproduction and Genome Organization. J. Clin. Microbiol. 2015, 53, 1655–1661. [Google Scholar] [CrossRef]
- Vermeersch, L.; Perez-Samper, G.; Cerulus, B.; Jariani, A.; Gallone, B.; Voordeckers, K.; Steensels, J.; Verstrepen, K.J. On the duration of the microbial lag phase. Curr. Genet. 2019, 65, 721–727. [Google Scholar] [CrossRef] [PubMed]
- Deschuyffeleer, N.; Audenaert, K.; Samapundo, S.; Ameye, S.; Eeckhout, M.; Devlieghere, F. Identification and characterization of yeasts causing chalk mould defects on par-baked bread. Food Microbiol. 2011, 28, 1019–1027. [Google Scholar] [CrossRef]
- Widyarani; Butar Butar, E.S.; Dara, F.; Hamidah, U.; Sriwuryandari, L.; Hariyadi, H.R.; Sintawardani, N. Distribution of protein fractions in tofu whey wastewater and its potential influence on anaerobic digestion. IOP Conf. Ser. Earth Environ. Sci. 2019, 277, 012012. [Google Scholar] [CrossRef]
- Marrero, Y.; Montoya, C.A.; Ruiz, O.; Elías, A.; Madera, N. Growth of Pichia guilliermondii strain Levica 27 in different energy sources and nitrogen. Cuban J. Agric. Sci. 2015, 49, 47–52. [Google Scholar]
- Narendranath, N.V.; Power, R. Relationship between pH and Medium Dissolved Solids in Terms of Growth and Metabolism of Lactobacilli and Saccharomyces cerevisiae during Ethanol Production. Appl. Environ. Microbiol. 2005, 71, 2239–2243. [Google Scholar] [CrossRef] [PubMed]
- Angulo-Montoya, C.; Ruiz-Barrera, O.; Castillo, Y.; Marrero, Y.; Elías, A.; Arzola, C.; Mancillas, P.F.; Díaz, D. Growth Dynamics and Metabolites Produced in the Fermentation of Candida Norvegensis Yeast. Cuban J. Agric. Sci. 2013, 47, 179–182. [Google Scholar]
- Shetty, P.H.; Jespersen, L. Saccharomyces cerevisiae and lactic acid bacteria as potential mycotoxin decontaminating agents. Trends Food Sci. Technol. 2006, 17, 48–55. [Google Scholar] [CrossRef]
- Xing, Y.; Chen, C.; Sun, W.; Zhang, B.; Sang, Y.; Xiu, Z.; Dong, Y. An environment-friendly approach to isolate and purify glucan from spent cells of recombinant Pichia pastoris and the bioactivity characterization of the purified glucan. Eng. Life Sci. 2018, 18, 227–235. [Google Scholar] [CrossRef]
- Piotrowska, M.; Masek, A. Saccharomyces Cerevisiae Cell Wall Components as Tools for Ochratoxin A Decontamination. Toxins 2015, 7, 1151–1162. [Google Scholar] [CrossRef]
- Many, J.N.; Vizhi, K. Analysis of Different Extraction Methods on the Yield and Recovery of β-Glucan from Baker’s Yeast (Saccharomyces cerevisiae). Int. J. Innov. Sci. Eng. Technol. 2014, 1, 268–271. [Google Scholar]
- Hatoum, R.; Labrie, S.; Fliss, I. Antimicrobial and Probiotic Properties of Yeasts: From Fundamental to Novel Applications. Front. Microbiol. 2012, 3, 421. [Google Scholar] [CrossRef] [PubMed]
- Ozmen Togay, S.; Capece, A.; Siesto, G.; Aksu, H.; Sandikci Altunatmaz, S.; Yilmaz Aksu, F.; Romano, P.; Karagul Yuceer, Y. Molecular characterization of yeasts isolated from traditional Turkish cheeses. Food Sci. Technol. 2020, 40, 871–876. [Google Scholar] [CrossRef]
- Odhiambo, B.O.; Murage, H.; Wagara, I.N. Screening for Atoxigenic Aspergillus Species and Evaluating their Inhibitory Potential against Growth and Sporulation of Aflatoxigenic Aspergillus Species. Egerton. J. Sci. Technol. 2014, 14, 61–80. [Google Scholar]
- Sudini, H.; Srilakshmi, P.; Kumar, K.V.K.; Njoroge, S.M.C.; Osiru, M.; Seetha, A.; Waliyar, F. Detection of aflatoxigenic Aspergillus strains by cultural and molecular methods: A critical review. Afr. J. Microbiol. Res. 2015, 9, 484–491. [Google Scholar] [CrossRef]
- Krijgsheld, P.; Bleichrodt, R.; van Veluw, G.J.; Wang, F.; Müller, W.H.; Dijksterhuis, J.; Wösten, H.A.B. Development in Aspergillus. Stud. Mycol. 2013, 74, 1–29. [Google Scholar] [CrossRef]
- Klich, M.A. Aspergillus flavus: The major producer of aflatoxin. Mol. Plant. Pathol. 2007, 8, 713–722. [Google Scholar] [CrossRef] [PubMed]
- Madrigal-Bujaidar, E.; Morales-González, J.A.; Sánchez-Gutiérrez, M.; Izquierdo-Vega, J.A.; Reyes-Arellano, A.; Álvarez-González, I.; Pérez-Pasten, R.; Madrigal-Santillán, E. Prevention of Aflatoxin B1-Induced DNA Breaks by β-D-Glucan. Toxins 2015, 7, 2145–2158. [Google Scholar] [CrossRef] [PubMed]
- Nazhand, A.; Durazzo, A.; Lucarini, M.; Souto, E.B.; Santini, A. Characteristics, Occurrence, Detection and Detoxification of Aflatoxins in Foods and Feeds. Foods 2020, 9, 644. [Google Scholar] [CrossRef] [PubMed]
- Iram, W.; Anjum, T.; Iqbal, M.; Ghaffar, A.; Abbas, M.; Khan, A.M. Structural Analysis and Biological Toxicity of Aflatoxins B1 and B2 Degradation Products Following Detoxification by Ocimum basilicum and Cassia fistula Aqueous Extracts. Front. Microbiol. 2016, 7, 1105. [Google Scholar] [CrossRef]
- Camilli, G.; Tabouret, G.; Quintin, J. The Complexity of Fungal β-Glucan in Health and Disease: Effects on the Mononuclear Phagocyte System. Front. Immunol. 2018, 9, 673. [Google Scholar] [CrossRef] [PubMed]
- Aazami, M.H.; Nasri, M.H.F.; Mojtahedi, M.; Mohammadi, S.R. In Vitro Aflatoxin B1 Binding by the Cell Wall and (1→3)-β-d-Glucan of Baker’s Yeast. J. Food Prot. 2018, 81, 670–676. [Google Scholar] [CrossRef]
- Intanoo, M.; Kongkeitkajorn, M.B.; Pattarajinda, V.; Bernard, J.K.; Callaway, T.R.; Suriyasathaporn, W.; Phasuk, Y. Isolation and screening of aflatoxin-detoxifying yeast and bacteria from ruminal fluids to reduce aflatoxin B 1 contamination in dairy cattle feed. J. Appl. Microbiol. 2018, 125, 1603–1613. [Google Scholar] [CrossRef] [PubMed]





| Parameter | Description | Figure |
|---|---|---|
| Macroscopic | ![]() | |
| Color | Brownish white | |
| Colony size | 0.2–0.3 cm | |
| Shape and edge | Round, Smooth | |
| Elevation | Embossed, Surface | |
| Appearance | No hyphae, smelly | |
| Microscopic | ![]() | |
| Cell shape | Ovoid | |
| Cell Size | 2.95–6.20 μm | |
| Reproduction | Budding | |
| Description | Results |
|---|---|
| Species | Pichia norvegensis culture CBS: 1953 |
| Maximum score | 737 |
| Total score | 737 |
| Query coverage | 100% |
| e-value | 0.0 |
| Percent Identity | 100% |
| Treatment | Contents (Ppb) | Reduction (%) | ||||
|---|---|---|---|---|---|---|
| AFB1 | AFB2 | Total | AFB1 | AFB2 | Total | |
| A. flavus (control) | 5417.69 ± 154.41 | 173.31 ± 20.93 | 5591.00 ± 144.34 | |||
| A. flavus + P. norvegensis NYI | 3954.38 ± 53.50 | 133.24 ± 1.13 | 4087.62 ± 54.63 | 36.97 ± 3.07 | 23.01 ± 3.82 | 26.85 ± 2.87 |
| A. flavus + β-glucan | 3946.81 ± 20.93 | 116.62 ± 0.49 | 4063.43 ± 21.42 | 27.13 ± 1.69 | 32.59 ± 4.20 | 27.30 ± 1.49 |
Publisher’s Note: MDPI stays neutral with regard to jurisdictional claims in published maps and institutional affiliations. |
© 2021 by the authors. Licensee MDPI, Basel, Switzerland. This article is an open access article distributed under the terms and conditions of the Creative Commons Attribution (CC BY) license (https://creativecommons.org/licenses/by/4.0/).
Share and Cite
Utama, G.L.; Suraloka, M.P.A.; Rialita, T.; Balia, R.L. Antifungal and Aflatoxin-Reducing Activity of β-Glucan Isolated from Pichia norvegensis Grown on Tofu Wastewater. Foods 2021, 10, 2619. https://doi.org/10.3390/foods10112619
Utama GL, Suraloka MPA, Rialita T, Balia RL. Antifungal and Aflatoxin-Reducing Activity of β-Glucan Isolated from Pichia norvegensis Grown on Tofu Wastewater. Foods. 2021; 10(11):2619. https://doi.org/10.3390/foods10112619
Chicago/Turabian StyleUtama, Gemilang Lara, Mahardhika Puspa Arum Suraloka, Tita Rialita, and Roostita Lobo Balia. 2021. "Antifungal and Aflatoxin-Reducing Activity of β-Glucan Isolated from Pichia norvegensis Grown on Tofu Wastewater" Foods 10, no. 11: 2619. https://doi.org/10.3390/foods10112619
APA StyleUtama, G. L., Suraloka, M. P. A., Rialita, T., & Balia, R. L. (2021). Antifungal and Aflatoxin-Reducing Activity of β-Glucan Isolated from Pichia norvegensis Grown on Tofu Wastewater. Foods, 10(11), 2619. https://doi.org/10.3390/foods10112619